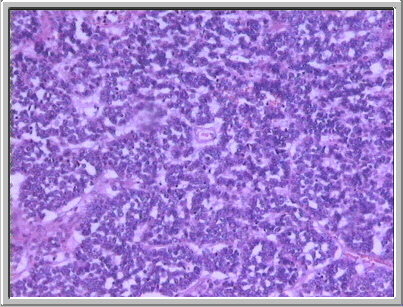
fig. 10
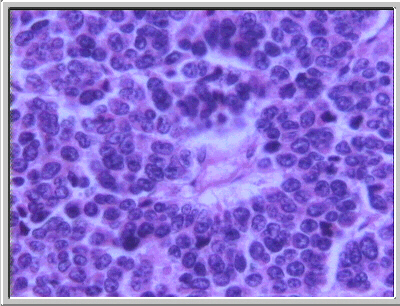
fig. 11
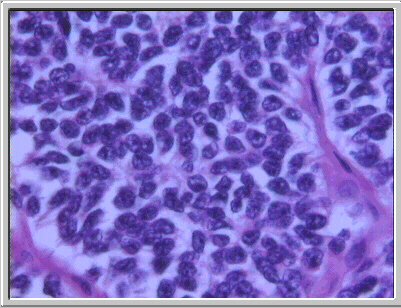
fig. 14

|
 |
|
Fig. 8. Extensas áreas de necrosis de coagulación. (HE, X40.) |
Fig. 9. Manguitos perivasculares de células tumorales viables en el interior de las áreas de necrosis. (HE, X100.) |
|
|
|
Fig. 10. Focalmente, el tumor presenta un patrón de crecimiento más organoide con imágenes trabeculares y «en guirnalda». (HE, X100.) |
Fig. 11. Imagen de roseta perivascular de las células tumorales en las áreas con patrón más organoide. (HE, X400.) |
 |
 |
|
Fig. 12. Imagen con patrón arquitectural en grandes nidos celulares con disposición en empalizada de las células periféricas de los mismos. (HE, X40.) |
Fig. 13. Patrón reticulínico en las áreas de grandes nidos celulares. (Reticulina, X40.) |
|
|
Fig. 14. Aspecto de las células tumorales a gran aumento. Se observan núcleo hipercromático, escaso citoplasma, atipia citológica (pleo y polimorfismo nucleares) y nucléolo poco aparente. (HE, X400.) |